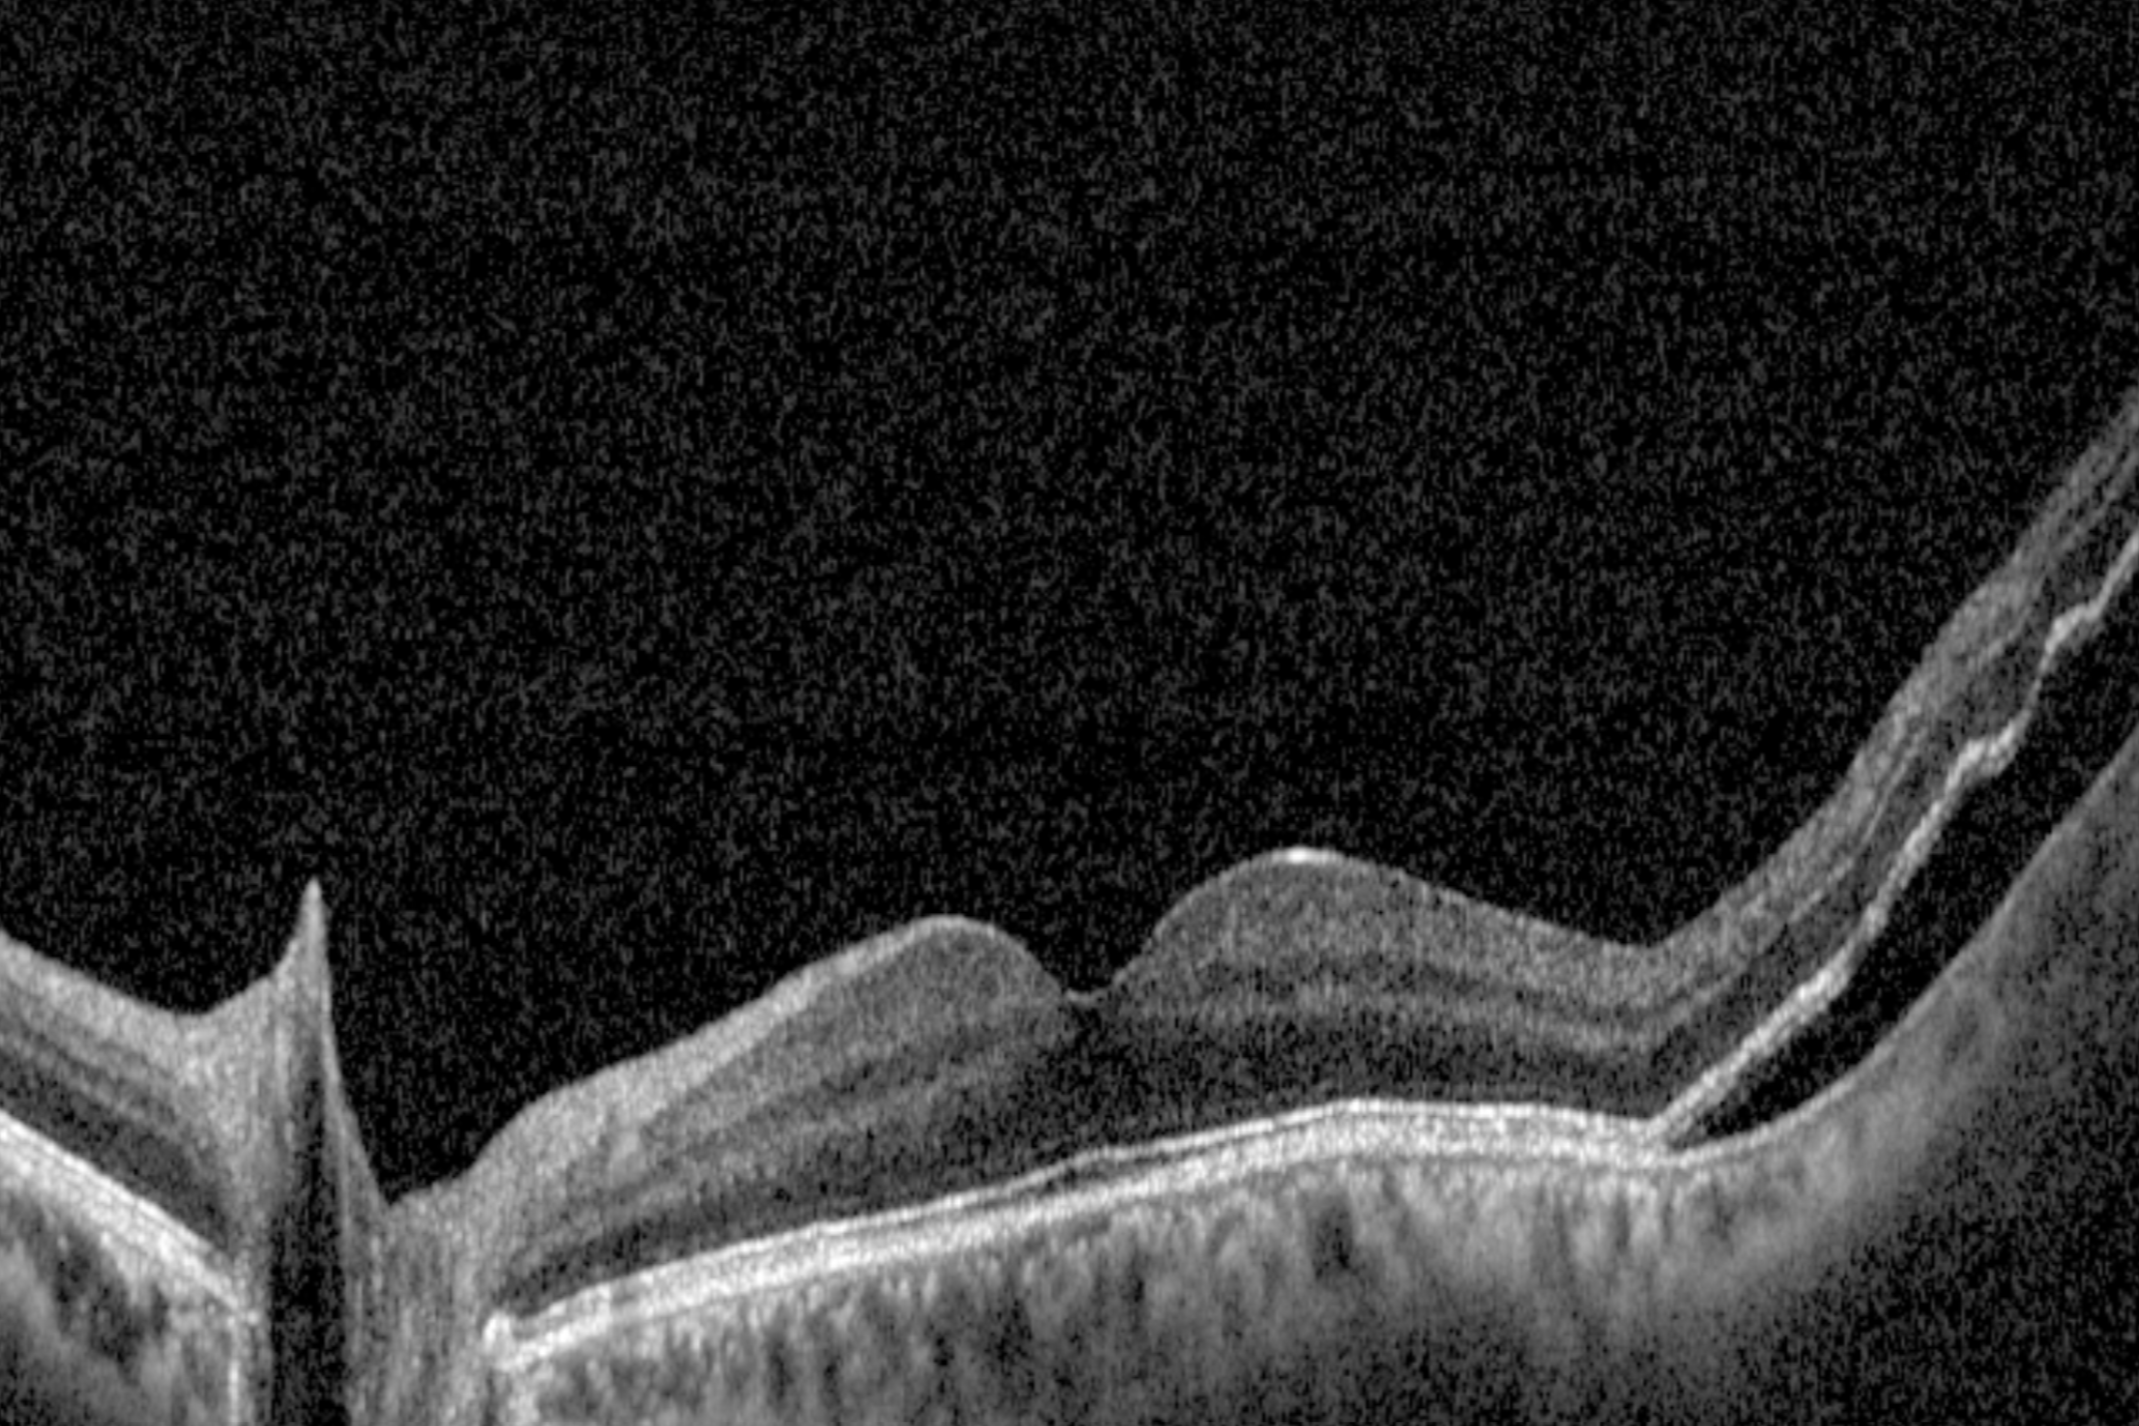
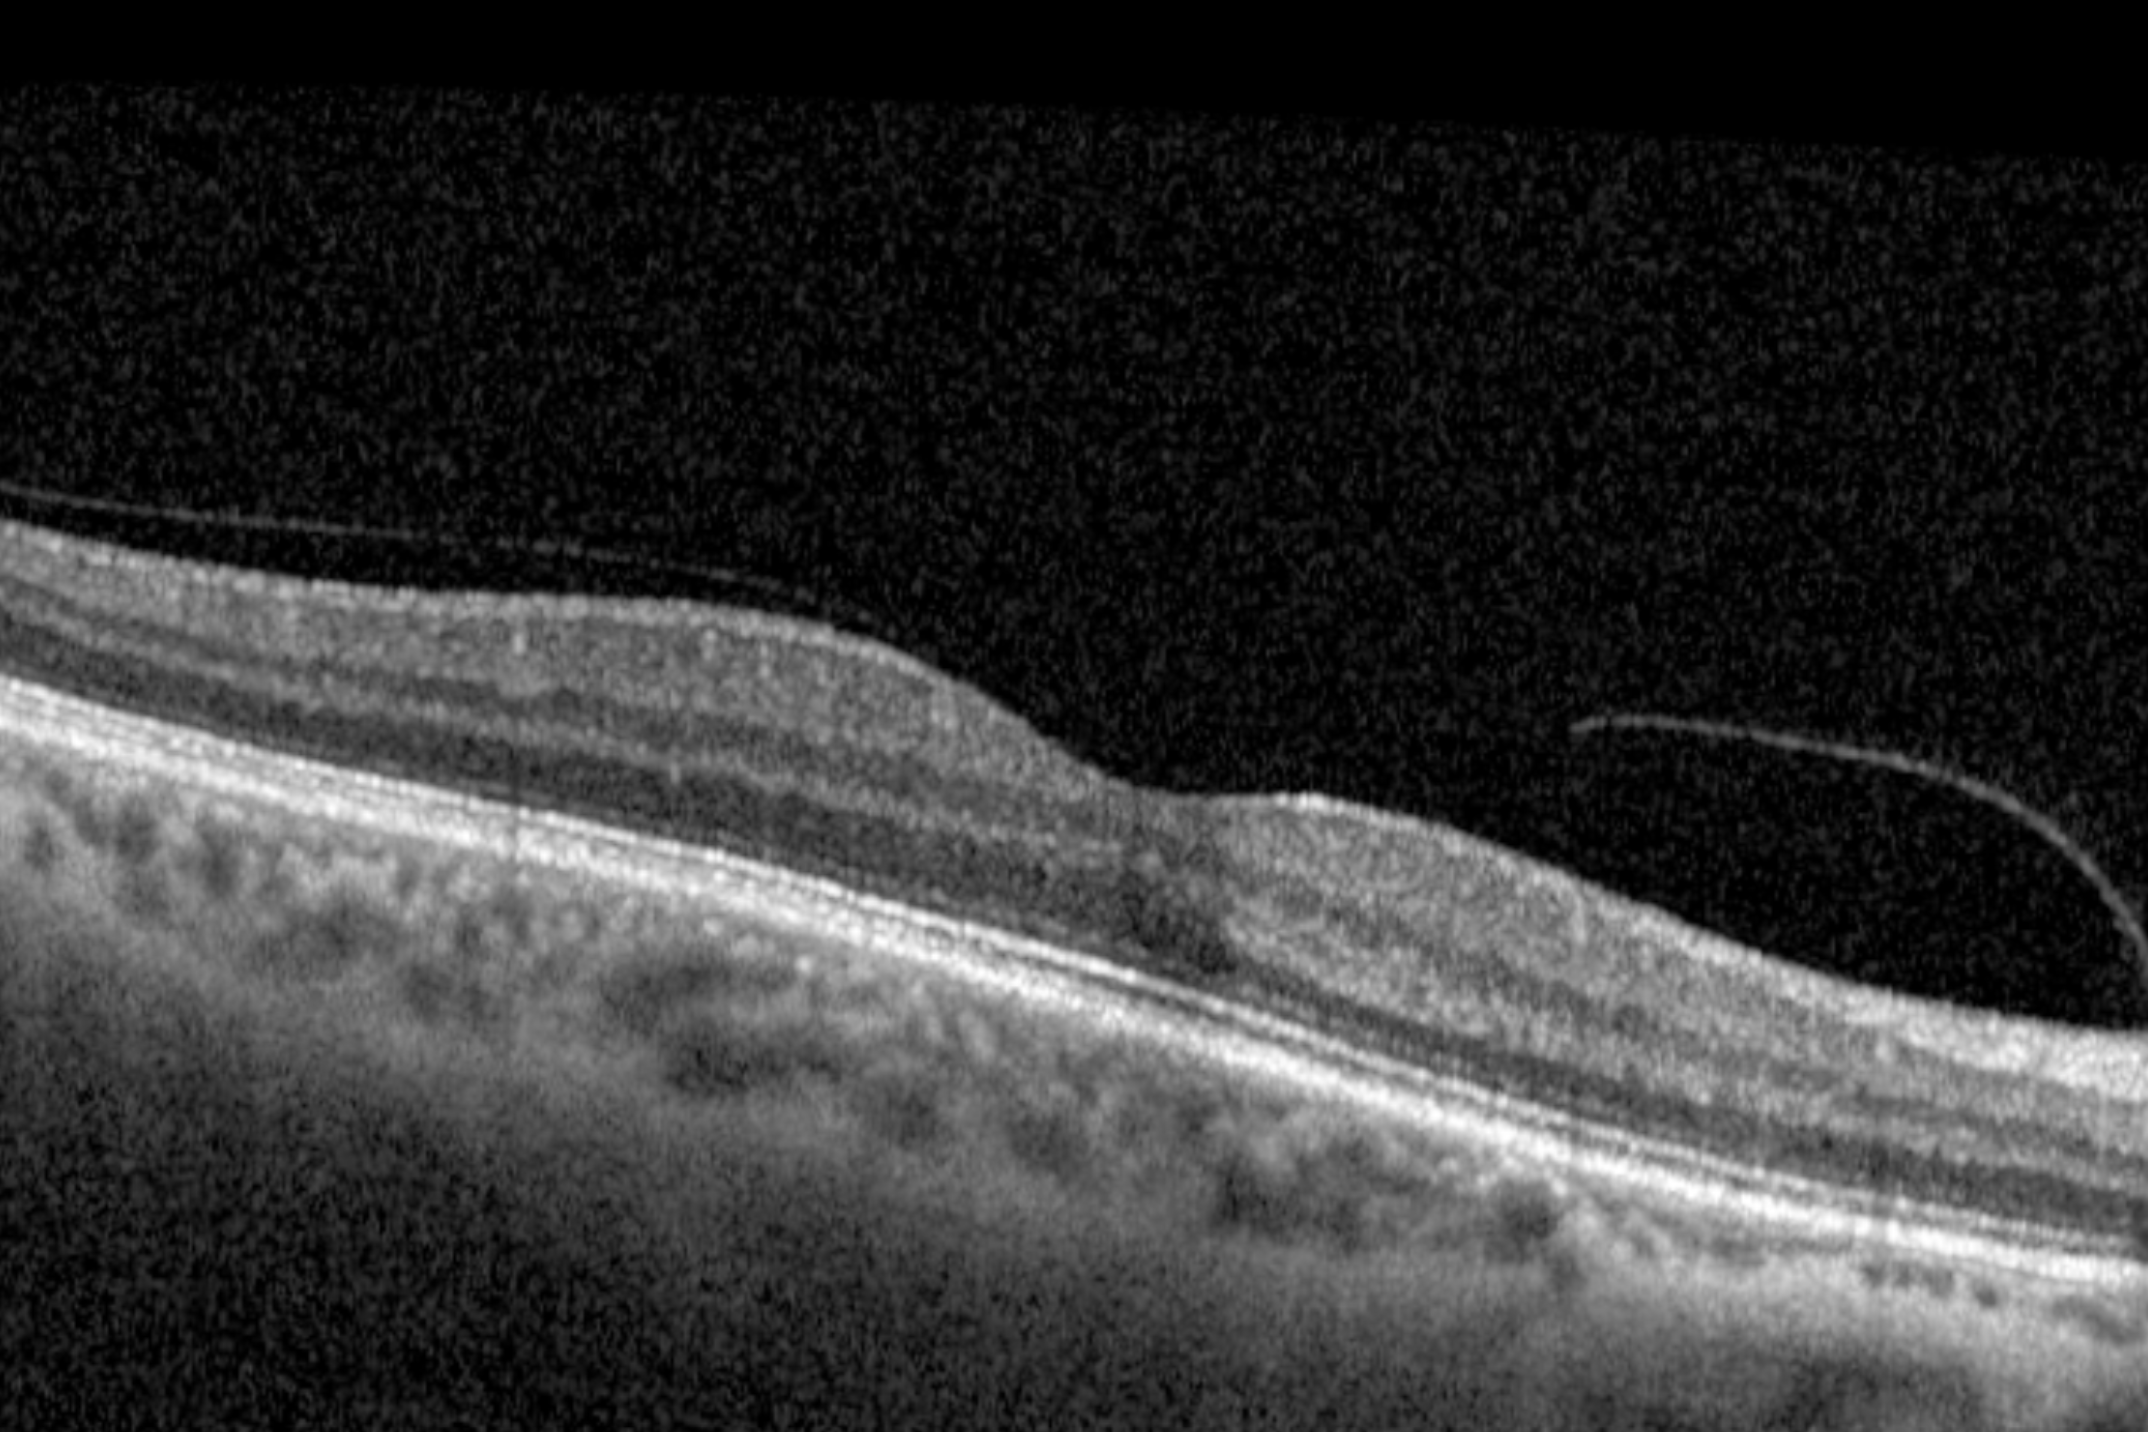

If you notice flashes of light, new floaters, or a shadow across your vision, it could be a warning sign of a retinal tear or detachment. These conditions require urgent care to prevent permanent vision loss.
At Innovative Eye Care, our Adelaide optometrists provide immediate assessment, diagnosis, and referral when necessary.


Floaters appear as specks, dots, or cobwebs in your vision.
Most are harmless, but a sudden increase in floaters or flashes may indicate a retinal tear.

Patients often search “symptoms of retinal tear”. These include:
If untreated, a retinal tear can progress to a retinal detachment.
Searches like “early signs of retinal detachment” reflect urgent intent. Warning signs include:
This is a medical emergency, same-day assessment is critical.
A posterior vitreous detachment is common with age and often harmless. However, because PVD can cause traction, it sometimes leads to retinal tears or detachment. Our optometrists can confirm the diagnosis with a dilated fundus exam.

We use dilated fundus exams, scleral depression, and retinal imaging to carefully examine the retina. This ensures tears or detachments are identified early.
Urgent Eye Care in Adelaide
If you notice:
Book an urgent eye exam in Adelaide immediately.